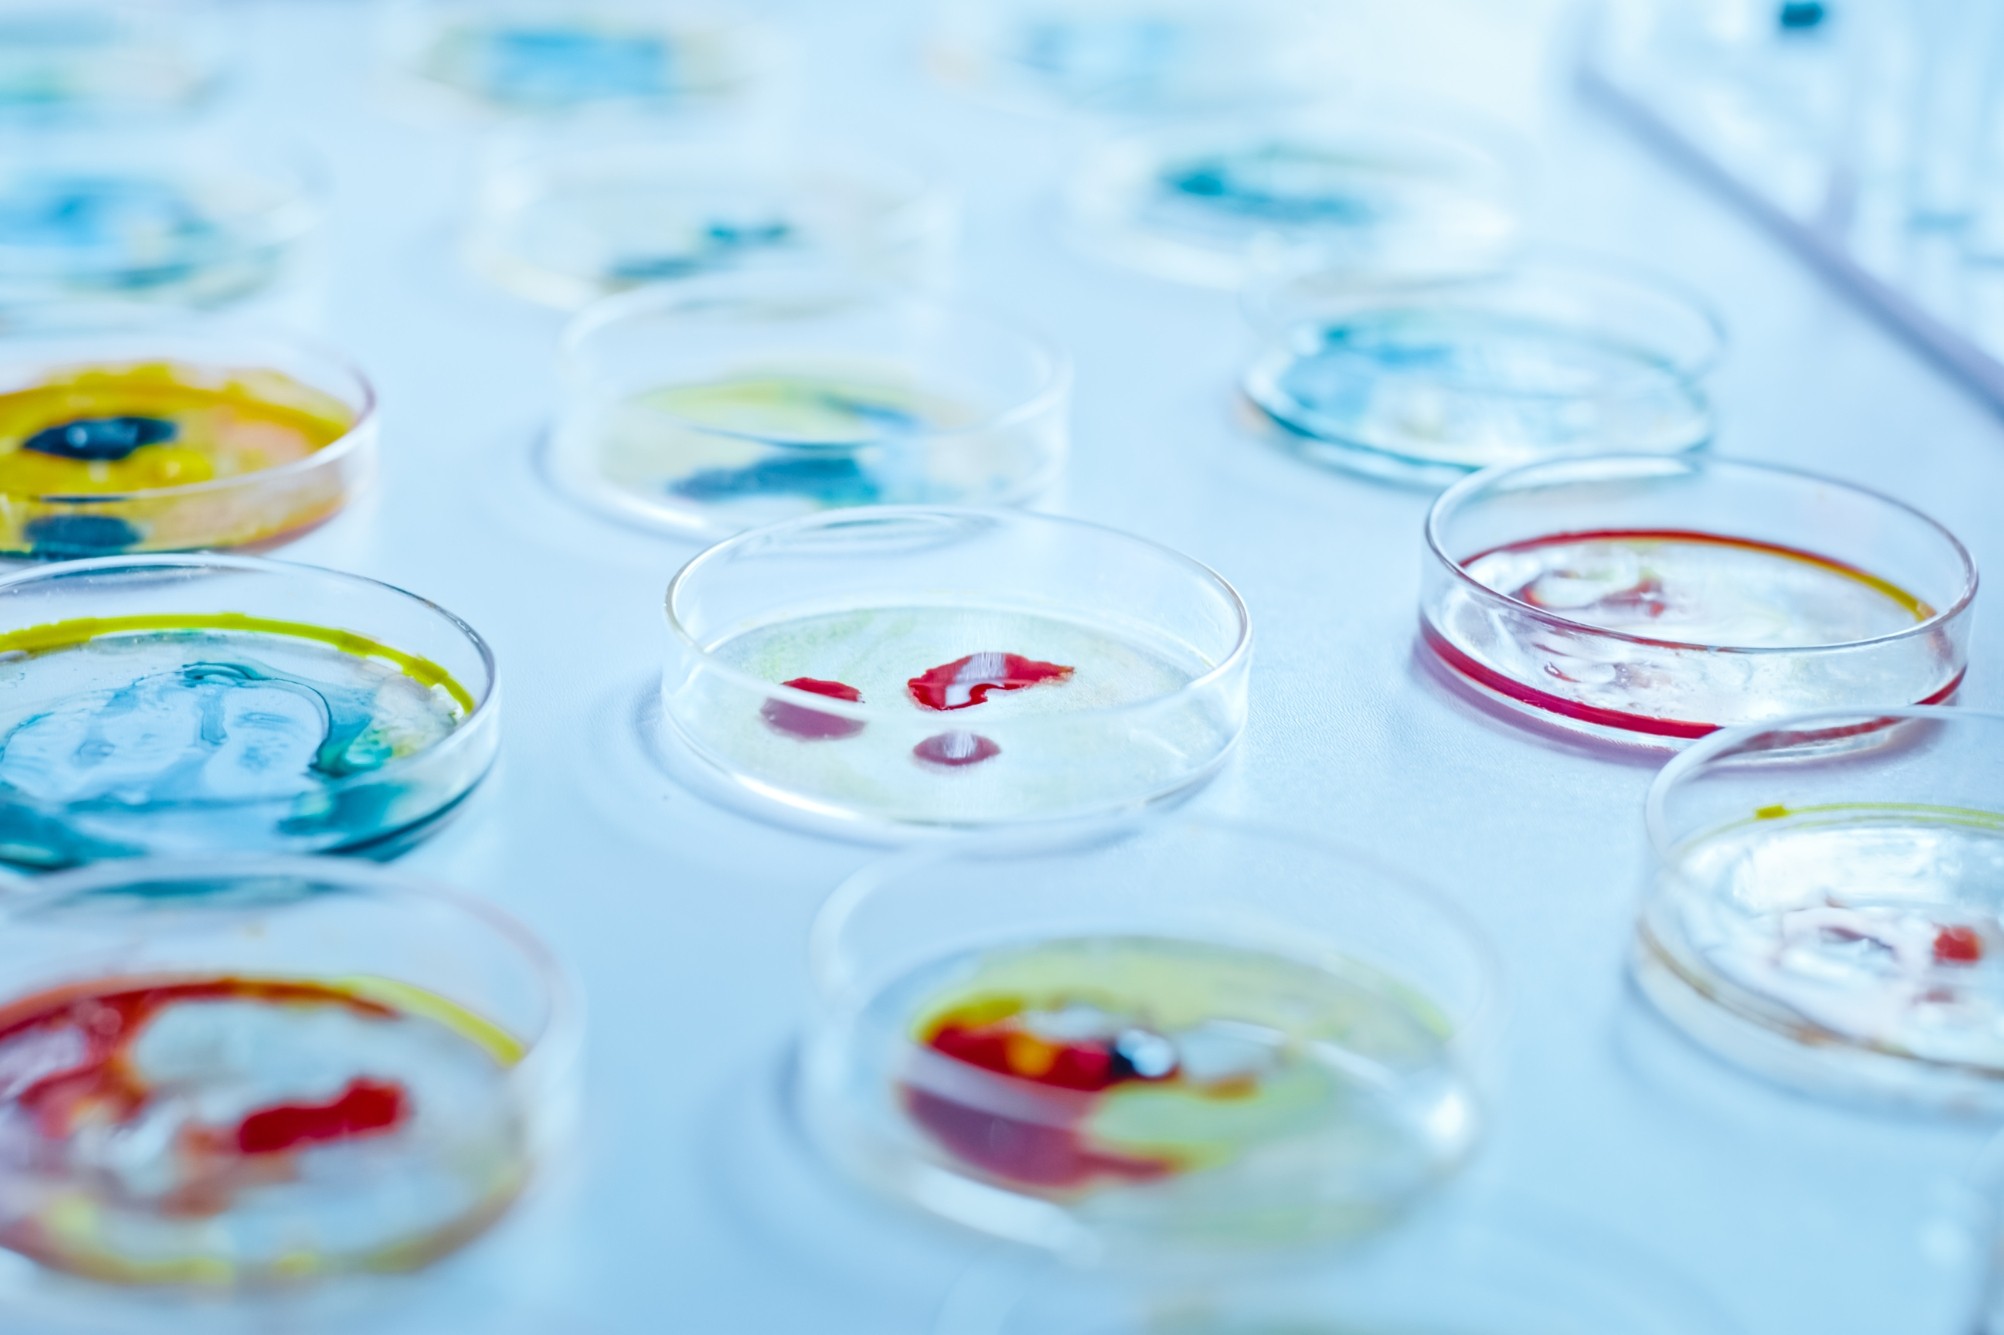

Engineered Human Therapies
Cutting-Edge Cure: CRISPR Sparks Hope for Rare Immune Disorder
Feb 6, 2024
gorodenkoff (Canva)
Researchers from the Max Delbrück Center have unveiled a promising avenue for tackling familial hemophagocytic lymphohistiocytosis (FHL), a rare and often fatal immune disorder affecting infants and young children. Published in Science Immunology, the research outlines a novel therapeutic approach employing the CRISPR-Cas9 gene-editing tool to rectify hereditary genetic defects responsible for triggering an aberrant immune response.
FHL, characterized by a malfunctioning immune system, typically manifests in infants under 18 months old and has a markedly high mortality rate. The ailment arises from mutations that prevent the normal function of cytotoxic T cells, immune cells that normally kill virus-infected or otherwise altered cells. When afflicted with viruses like Epstein-Barr (EBV), these compromised T cells fail to eliminate infected cells, triggering an uncontrolled immune reaction known as a cytokine storm, affecting the entire body.
“Doctors treat FHL with a combination of chemotherapy, immunosuppression, and bone marrow transplantation, but many children still die of the disease,” says Professor Klaus Rajewsky, who heads the Immune Regulation and Cancer Lab at the Max Delbrück Center. Recognizing the urgent need for more effective interventions, Professor Rajewsky and his team turned to CRISPR-Cas9. Their approach involved manipulating the perforin gene in mice to replicate the genetic defects seen in FHL patients. When they then elicited a condition resembling an EBV infection, the affected B cells multiplied uncontrollably because the defective cytotoxic T cells were unable to eliminate them. The team next collected T memory stem cells – long-lived T cells from which active cytotoxic T cells can mature – from the blood of the mice. By employing CRISPR-Cas9, the researchers successfully corrected the defects in these cells and reintroduced these cells into the mice, and their symptoms disappeared as immune function returned to normal.
Dr. Xun Li, the study's lead author, extended these findings to human subjects to demonstrate the feasibility and precision of the gene repair technique. “Our gene repair technique is more precise than previous methods, and the T cells are virtually unchanged after undergoing gene editing,” says Li. “It was also fascinating to see how effectively the memory T cells could be multiplied and repaired from even a small amount of blood.” Blood samples from infants afflicted with FHL revealed promising outcomes, with repaired T memory cells exhibiting a restored cytotoxic T cell response in cell culture experiments.
While these results offer hope, critical questions remain unanswered. Dr. Christine Kocks, a scientist in Rajewsky’s team, emphasizes the need for rigorous clinical trials to ascertain the therapy's long-term efficacy and safety. “It is still uncertain how long the protective effect lasts,” says Kocks. “Since the T memory stem cells remain in the body for a long time, we hope the therapy provides long-term or even permanent protection. It is also conceivable that patients could be treated with their repaired T cells over and over again.”
Nonetheless, the minimally invasive procedure, requiring only a small blood sample, presents a promising alternative to conventional treatments like bone marrow transplants, which require additional preparatory treatment. “We very much hope that our mechanism of action is a breakthrough in treating FHL,” says Rajewsky, “either to gain more time for a successful bone marrow transplant or even as a treatment itself.”